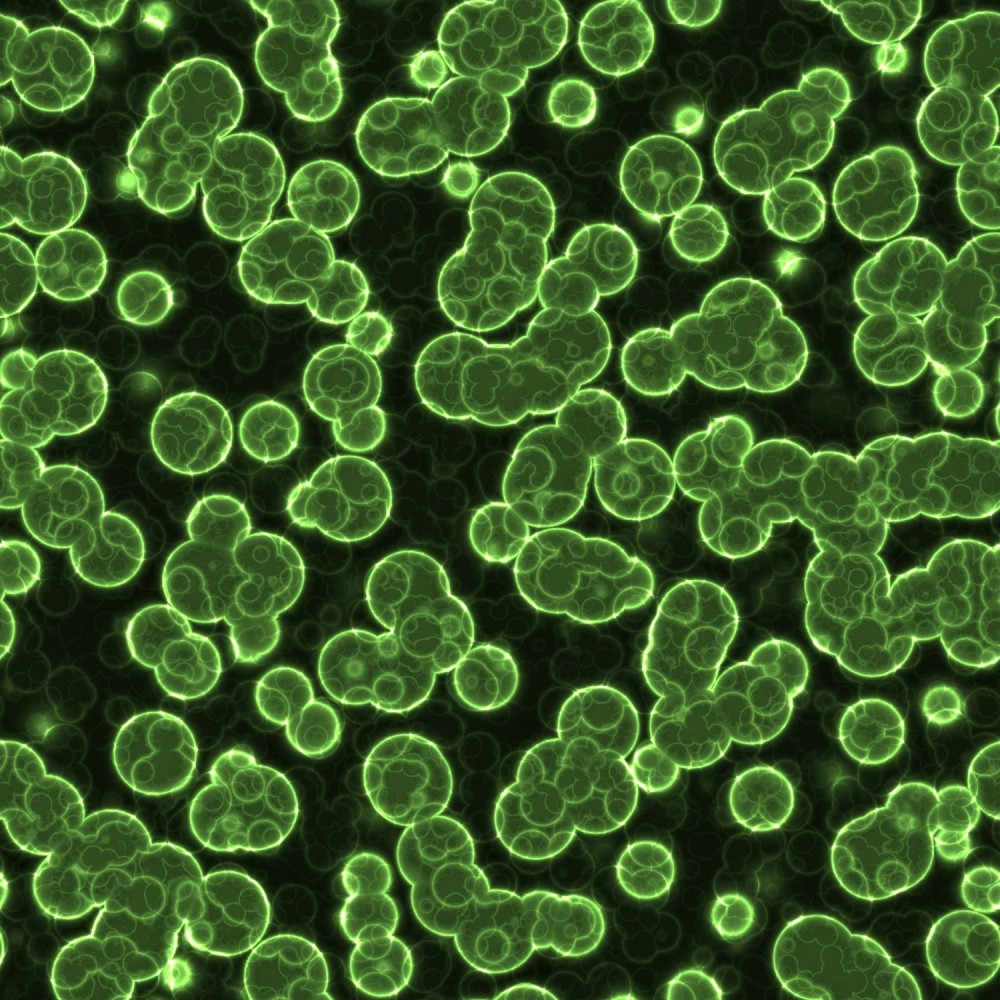
Ove stvari izbacite na vreme iz kuće, inače vam se loše piše

Tema: prljavština
 RAZBIJAMO MIT
RAZBIJAMO MIT
Čuveno pravilo "5 sekundi" je najbolji izgovor. Da li znate šta znači?
NEMOJTE RIZIKOVATI
NEMOJTE RIZIKOVATI
Ove stvari izbacite na vreme iz kuće, inače vam se loše piše

Tastatura prljavija od WC-šolje
 DRAMA!
DRAMA!
Zadrugarima preti zaraza, pacovi se pojavili u spavaćoj sobi! Za sve je kriva ONA!
 STRUČNJACI UPOZORAVAJU
STRUČNJACI UPOZORAVAJU
Ako ste zatekli automobil prekriven blatom, ne perite ga!

SVUDA SU DLAKE I GLIBAVE GAĆE! Odvratan prizor u Zadruzi, da se čovek ispovraća!
 SAMO KAPNEŠ I GOTOVO
SAMO KAPNEŠ I GOTOVO
Ovaj sastojak kao od šale čisti masnoću i prljavštine
 IMUNITET
IMUNITET
Za decu je zdravo da se isprljaju
 MENJAJTE NAVIKE
MENJAJTE NAVIKE
Ovo su šest uzroka masne kose!
 SHVATILI IZ PRVE
SHVATILI IZ PRVE
Učiteljica na šokantan način učila decu o pranju ruku!
 KO BI REKAO?!
KO BI REKAO?!
Stavljamo je svakodnevno u usta, a prljavija je od wc šolje!
 OBATITE PAŽNJU
OBATITE PAŽNJU































Oprala je jastuk nakon 10 godina i podelila na internetu, a rezultat je sve zgrozio (VIDEO)